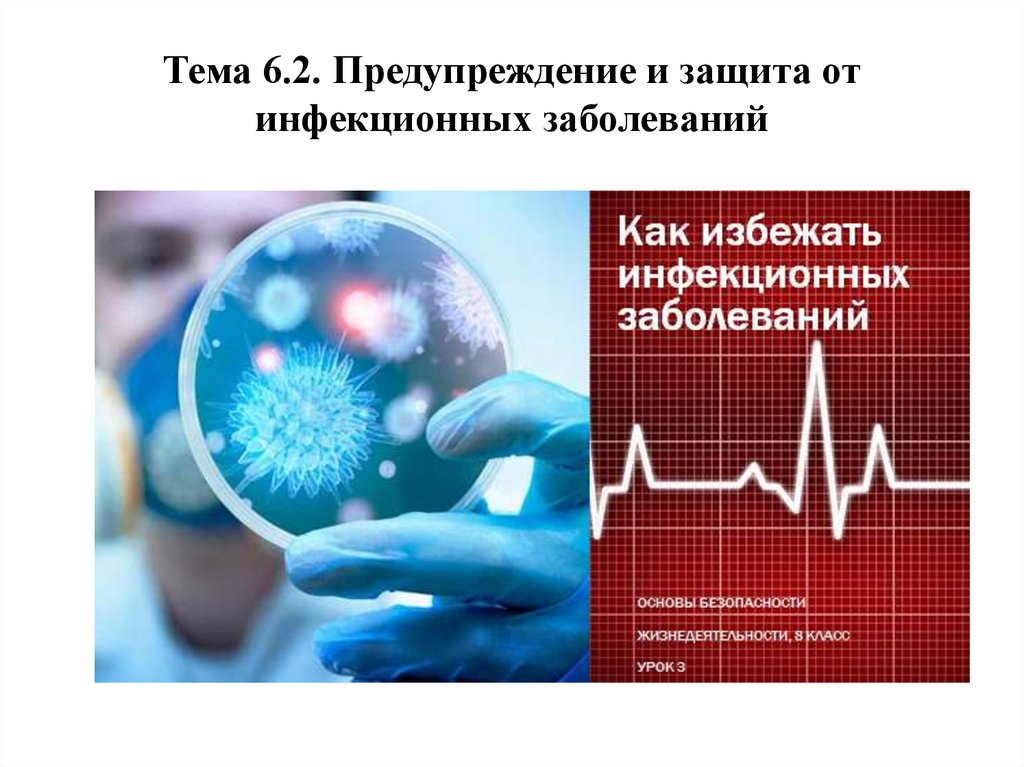

Similar presentations:
1c8f3a2e9e8c420394c44e54f0694e46
1. Тема 6.2. Предупреждение и защита от инфекционных заболеваний
2.
3.
4.
5.
6.
7.
8.
9.
10.
11.
12.
13.
14.
15.
16.
17.
18.
19.
20.
21.
22.
23. Ответы на вопросы
1.2.
3.
4.
5.
6.
7.
Дезинтерия
Ботулизм
Дезинфекция
Прививка
Гепатит
Эпидемия
Чесотка
24. Закрепление материала
1.2.
3.
4.
5.
6.
7.
Кишечная инфекция, заболевание грязных рук.
Заболевание от употребления недоброкачественных продуктов.
Обработка всех предметов и жилья, которыми пользовался
инфекционный больной.
Инъекция (укол) от инфекционного заболевания для выработки
иммунитета.
Вирусное заболевание, поражающее печень.
Массовое заболевание населения инфекционными болезнями.
Инфекционное кожное заболевание, вызывающее сильный зуд.
25.
1. Конспект занятия по теме: «Инфекционные заболевания»2. Ответить письменно на 4 вопроса:
- Что такое инфекционные заболевания и как они возникают?
- Каковы симптомы инфекционных заболеваний?
- Чем отличаются грипп от ОРВИ?
- Если вы заболели, как нужно себя вести, чтобы не получить осложнений?
3. Ресурсы Интернета (в поисковой строке печатаете «Инфекционные заболевания.
ОБЖ 8 класс» и нажимаете « Найти» и изучаете открывшийся материал.